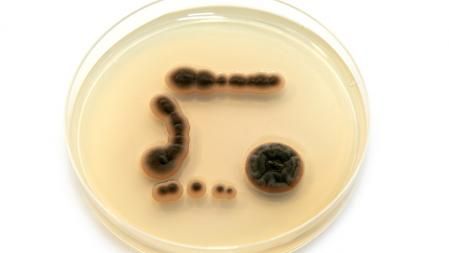
Microorganismos modificados genéticamente en placa de agar

Verano es sinónimo de calor y playa. Una gran cantidad de personas se desplazan a las costas españolas durante el período vacacional y una vez allí uno de los pasatiempos preferidos es ir a la playa. Al lado del mar pasamos mucho más tiempo en la arena que en el agua. Sin embargo, al igual que leemos frecuentemente noticias acerca de la calidad del agua, no solemos leer nada relacionado con la arena de las playas, pese a que es caldo de cultivo de organismos microscópicos.
Hay muchos microorganismos, también llamados microbios, presentes en la arena de la playa, pero el riesgo de infección no es muy alto. Un microorganismo o microbio es un organismo de tamaño muy pequeño, que solo se puede ver con la ayuda de un microscopio.

Hay que evitar que nos niños se lleven la arena de la playa a la boca
Parásitos, virus, bacterias y hongos son habituales de la arena, junto a muchos otros. En realidad, hay muchos miles de organismos a la orilla del mar. Para saber con exactitud qué tipo de seres vivos habitan la arena playera, la Organización Mundial de la Salud (OMS) encargó un estudio que analizó arenas de diversas playas e identificó el tipo de organismo que viven allí.

En la arena de la playa se encuentran una gran cantidad de microorganismos
Una gran diversidad de seres vivos
Este informe señala la presencia en la arena de bacterias, hongos, parásitos y virus, la gran mayoría de los cuales son inofensivos. Aunque los estudios epidemiológicos reflejados en el citado informe no han demostrado la posibilidad de contagio de enfermedades a través de la arena de la playa, las conclusiones del estudio indican que la arena de la playa podría actuar como reservorio de seres vivos, es decir, que aloja una gran diversidad de microorganismos.
Los microorganismosmás frecuentes en la playa
1Escherichia coli
2Salmonella
3Campylobacter
4Microsporum nanum
5Trichophyton mentagrophytes
6Trichophyton rubrum
Entre los microorganismos que se hallan con más frecuencia en la playa están aquellos que afectan a nivel digestivo, como por ejemplo el escherichia coli, la salmonella y el campylobacter. Todos estos microorganismos pueden provocar síntomas comunes como vómitos, diarreas y otros problemas digestivos. Junto a estos, también se pueden encontrar con facilidad hongos como microsporum nanum, trichophyton mentagrophytes y trichophyton rubrum. Estos hongos pueden producir infecciones dermatológicas. El estudio liderado por la OMS no logró encontrar cantidades significativas de virus y parásitos y, al parecer, el volumen de estos pequeños organismos depende de la época del año.
Precauciones
que hay que seguir
Cuidado con los niños
Vigilar que los más pequeños no se ponga arena en la boca
Una buena ducha
Realizar higiene profunda del cuerpo tras un día en la playa
Microorganismos modificados genéticamente en placa de agar
La posibilidad de infección en la playa a causa del contacto con estos microorganismos no es preocupante y es prácticamente igual que en cualquier otro lugar. De todos modos, es conveniente vigilar con atención a los niños cuando están jugando en la playa y evitar que se pongan arena en la boca. Lógicamente, también hemos de realizar una higiene profunda del cuerpo tras finalizar la jornada playera.
 PortalCLÍNIC es un proyecto del Hospital Clínic y la Fundación BBVA. La información del artículo ha sido elaborada en colaboración con PortalClínic, del Hospital Clínic de Barcelona y documentada por profesionales sanitarios.
PortalCLÍNIC es un proyecto del Hospital Clínic y la Fundación BBVA. La información del artículo ha sido elaborada en colaboración con PortalClínic, del Hospital Clínic de Barcelona y documentada por profesionales sanitarios.


